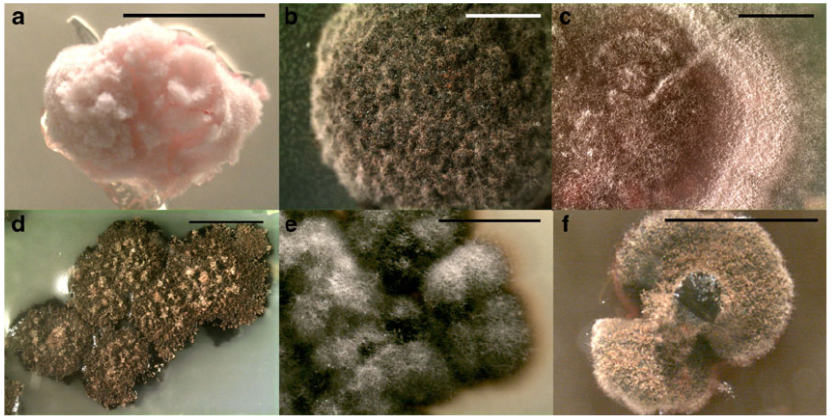
地衣化真菌培养物

25种地衣共生真菌培养技术详解
来源:武汉市灰藻生物科技有限公司 浏览量:111 发布时间:2026-01-31 12:13:15
Highlight
地衣真菌培养物,因稀缺且难以维持,相关实验材料十分有限。
为此,我们整理并翻译了英文论文《Twenty-five cultures of lichenizing fungi available for experimental studies on symbiotic systems》,以促进共生系统研究。
该研究成功培养,涵盖3个纲、5个目的25种地衣化真菌的技术方案,明确了关键培养基配方与培养维持策略,并将所有菌株保藏于公共菌种库,为地衣共生系统的实验生物学研究,提供了宝贵的生物材料资源。
关键要点
• 培养基优化:五种培养基可满足大多数地衣真菌的培养需求,但蓝细菌共生型地衣需特殊培养条件。
• 培养维护策略:液体培养需定期物理搅动,固体培养可长期保存,但需建立多备份体系。
• 基因组学突破:发现铵转运蛋白的水平基因转移事件,揭示地衣共生的分子进化特征。
• 资源开放共享:所有培养物存入公共菌种库,推动地衣共生系统研究的标准化和可重复性。

摘要
描述了培养25种隶属于锤舌菌类(子囊菌门)三个纲、五个目的地衣共生菌所采用的技术。
我们发现,包括马铃薯胡萝卜培养基、麦芽提取物-酵母提取物培养基(MY)、含氮博尔德基础培养基(NMBBM)、燕麦片培养基,以及添加补充物的酵母提取物培养基(YES)在内的,五种培养基,能够有效诱导多种地衣化真菌的子囊孢子萌发,并适用于菌株的长期生长维持。
建议定期对液体培养基中的菌丝进行物理破碎,以持续促进其生长。本研究已对其中五种地衣共生菌株进行了全基因组测序。
通过测定各菌株的核糖体内转录间隔区(ITS)或线粒体小亚基(mitSSU)序列,验证了各培养物的分类身份。
此外,报告了各类群已测序基因的总数,以说明其测序覆盖水平。所有真菌培养物均已保藏于公共菌种库,可供科学界用于体外实验研究。
关键词:培养;地衣;真菌
引言
地衣真菌与藻类组分的培养尝试,几乎与地衣学这一学科领域同期开启。早在19世纪80年代,Bonnier (1887, 1889) 和 Stahl (1877) 便分别报道了成功培养地衣真菌的案例 (Stocker-Wörgötter 2001)。近一个世纪后,Ahmadjian (1966, 1973) 在推动地衣化真菌培养技术方面贡献卓著,他引入并完善了孢子喷射法 (Ahmadjian 1973)。此外,研究人员也成功地从粉芽(如 Armaleo 和 May 2009)以及地衣体碎片(Yamamoto 等 1985; Armaleo 1991; Yamamoto 等 1993)中分离出培养物。然而,尽管已有许多关于地衣共生真菌单独培养的报道(例如 Oliver 等 1989; Jahns 1993; Yamamoto 等 1993; Crittenden 等 1995; Stocker-Wörgötter 2001, 2002; Sangvichien 等 2011),但与保藏库中普遍存在的酵母和非地衣化丝状真菌相比(例如 CBS-KNAW 数据库),可公开获取的地衣化真菌培养物仍然很少。唯一的例外是美国模式培养物保藏中心所收藏的 Ahmadjian 提供的38株真菌共生体培养物。
公开可获取的地衣化真菌培养物相对匮乏,一个重要原因在于这些真菌的分离过程十分繁琐。尽管已有针对多种地衣化真菌的培养条件与营养需求的报道(例如 Bubrick 1988; Stocker-Wörgötter 1991; Crittenden 等 1995; Sangvichien 等 2011),但大多数地衣化真菌,尤其是那些生长缓慢的种类,其培养条件仍属未知。此外,即使已知培养条件,要建立纯培养也非易事。因为即便严格排除了外部的真菌和细菌污染,地衣体内部仍存在多种内生地衣真菌 (Arnold 等 2009; U'Ren 等 2010),它们的生长速度可能快于或等同于地衣化真菌。如果使用地衣体碎片来启动培养,这些污染物可能从中生长出来。因此,某些关于成功培养地衣化真菌的报道,实际上描述的可能正是内生地衣真菌。这些内生真菌绝大多数属于盘菌亚门中的丝状子囊菌,而所有地衣型子囊菌物种也属于该亚门 (Arnold 等 2009)。再者,对于大多数地衣化真菌以及几种最常见的地衣化藻类而言,地衣共生关系本质上是专性的,这意味着可能无法将某些地衣化真菌进行纯培养。
培养物稀少的另一主要原因在于,即使获得了纯培养,也可能难以维持。地衣化真菌在培养中生长缓慢,这意味着即使是生长缓慢的污染物也极易超过其生长速度。此外,地衣化真菌在液体培养中仅能生长数周,随后便似乎进入停滞状态。一旦培养物达到此阶段,必须对其进行物理破碎(例如使用匀浆器)以刺激其恢复生长 (Ahmadjian 1973)。而且,每一次转接和后续操作都带来污染的可能。
我们已在无菌条件下分离培养了来自25种地衣的真菌共生体。
这些培养物的获取,源于三个项目背景:
(1) "构建真菌生命之树"项目;
(2) 杜克大学与太平洋西北国家实验室合作,旨在对三种地衣的真菌和藻类共生体进行基因组测序的项目;
(3) 一项专注于地衣形成真菌中铵转运蛋白与DNA甲基化分子演化的博士论文研究 (McDonald 2011)。
"构建真菌生命之树"项目涉及从代表所有主要地衣形成真菌谱系及相关非地衣化真菌的63个物种中,对21个新的蛋白质编码基因进行测序。在大多数情况下,从地衣化真菌的培养物而非直接从地衣体中扩增DNA被认为是更佳选择,因为这排除了来自污染性内生真菌的DNA被扩增的可能性。此外,培养对于产生足量材料以扩增全部21个基因也是必要的。
在第二个项目中,杜克大学与太平洋西北国家实验室合作,对分别代表网衣亚纲(粗糙微泡衣)、茶渍亚纲(粉杆石蕊)和厚顶盘菌亚纲(丝光平盘衣)的三个地衣的真菌和藻类共生体进行了基因组测序,以比较研究地衣化的基因组学。通过比较这些系统发育上远缘的地衣中,其共生体在自由生活状态与共生状态下的基因表达谱,可以确定哪些(如有)基因或通路在地衣化过程中是进化保守的,这有可能揭示丝状子囊菌在进化过程中经历了多少次独立的地衣化起源。该项目的一个新颖之处在于,每种地衣的真菌和藻类培养物均源自同一地衣体,因此其基因组代表了自然界中实际存在的共生关系。
对地衣粉杆石蕊的真菌和藻类基因组研究揭示了地衣化的若干有趣方面。通过检查藻类基因组中是否有真菌来源的基因,以及真菌基因组中是否有推测为藻类来源的基因,探索了真菌与藻类之间水平基因转移的可能性。藻类基因组中未发现明显的从真菌到藻类的水平基因转移证据,但在真菌基因组中发现了两个类植物基因。这两个基因均编码铵转运蛋白 (McDonald 等 2012)。为了查明这一水平基因转移事件发生的进化时间点,我们对其他几种地衣化真菌进行了调查,以检测这些铵转运蛋白的存在。获取地衣真菌共生体的培养物对于确保扩增到的类植物铵转运蛋白确实来自真菌基因组、而非地衣藻类至关重要。
在DNA甲基化项目中,针对粉杆石蕊真菌基因组仅在其共生状态下存在广泛DNA甲基化的报道 (Armaleo 和 Miao 1999),我们通过对构成该地衣的真菌和藻类在自由生活及共生状态下的基因组进行亚硫酸氢盐测序来加以探究。
本文旨在描述我们从25种地衣(涵盖真菌的三个纲和五个目:包括网衣目、茶渍目、厚顶盘菌目、小核衣目和星盾炱目)中培养真菌共生体所采用的方法,以获取适用于基因组测序所需大量DNA的大规模培养物。
本文的主要目的是报告来自上述三项研究中已成功分离、并保藏于公共菌种库的菌株,以期为未来地衣共生系统的研究提供资源。同时,我们也报告了每个培养物已测序的基因数量或平均基因组覆盖度。
2 材料与方法
2.1 真菌共生体培养
将单个子囊盘或带有多个子囊盘的地衣体碎片进行清洗、吸干水分后,用双面胶或凡士林固定在倒置的培养皿盖内,以使孢子向上弹射到培养基上。将已萌发的孢子转接至固体培养基上,于20°C或室温下培养。
随后,将培养物转移至固体斜面,置于室温或4°C下进行长期保存。为获取用于DNA提取的大规模菌丝材料,将一块固体培养物与液体培养基在匀浆器中均质化,并于20°C摇床培养。为防止液体摇瓶培养物进入休眠状态,需每2至8周定期对培养物进行再次均质化处理。
使用的培养基:
麦芽提取物-酵母提取物培养基(MY)(Ahmadjian 1993)
基于含氮博尔德基础培养基的改良营养培养基(NMBBM)(Trembley 等 2002)
燕麦片培养基(10 g/L均质化燕麦片,Keller 等 1994)
马铃薯-胡萝卜培养基(方法参照 Simmons 1992,但配置为10倍母液,采用离心而非过滤步骤,据Dyer与Crittenden个人交流),
以及酵母提取物补充培养基(YES)(MP 产品目录号 #4101-532)
所有固体培养基均添加20 g/L琼脂,液体培养基则不添加。
孢子萌发后,将生长良好的培养物转移至NMBBM或MY斜面培养基上,这些培养基足以支持其持续生长,在某些情况下可维持一年或更长时间才需转接。
培养物凭证标本以水存方式保存,即将生长中培养物的一小块琼脂置于完全注满水的2 mL离心管中,存放于室温下(Arnold 等 2009)。
同时,采用硝化纤维素圆片在-80°C条件下保存冷冻菌种(方法依据 D. Armaleo 个人交流)。
2.2 DNA提取
将来自液体培养的菌丝材料用液氮速冻,随后在小型珠磨仪中用玻璃珠进行研磨(分三次,每次30秒,其间用液氮冷却),或在Eppendorf管中用金属刮刀研磨。
DNA提取采用基于 Zolan 和 Pukkila (1986) 所述碱裂解法并经 Gueidan 等 (2007) 修改的方案,并在此基础上进一步调整:即在加入提取缓冲液后,如有必要,可使用塑料研磨杵进一步匀浆组织。
2.3 DNA扩增与测序
为确认培养物的身份,使用引物 ITS1F (Gardes 和 Bruns 1993) 与 ITS4 (White 等 1990) 扩增核糖体RNA编码基因的内部转录间隔区(ITS),以及引物 mitSSU1 与 mitSSU3R (Zoller 等 1999) 扩增线粒体小亚基(mitSSU)。
PCR反应程序参照 McDonald 等 (2012) 和 Gaya 等 (2012)。经凝胶电泳检测后,使用 ExoSAP-IT (USB Corporation, Cleveland, OH) 或 Montage PCR 过滤单元 (Millipore, Billerica, MA, USA) 纯化PCR产物。
对于微弱的PCR产物,使用 Topo TA 克隆试剂盒 (InvitrogenTM, life technologies, Carlsbad, CA) 进行克隆。
测序反应在10 μL体系中进行,包含:1 μL 相应引物(ITS1F、ITS4、mitSSU1 或 mitSSU3R),1 μL 纯化后的PCR产物,0.75 μL Big Dye (Big Dye Terminator Cycle sequencing kit, ABI PRISM version 3.1; Perkin-Elmer, Applied Biosystems, Foster City, CA),3.25 μL Big Dye 缓冲液,以及4 μL 双蒸水。
反应产物的自动化纯化与检测在杜克大学基因组科学与政策研究所基因组测序与分析核心设施完成。纯化反应使用 Sephadex G-50 DNA级层析柱进行,用水洗脱。
随后,样品直接上样至 ABI 3730xl DNA 分析仪 (PE Applied Biosystems, Foster City, CA) 进行分析,采用22秒进样时间和50厘米毛细管阵列。
2.4 菌株保藏
本文报道的菌株在寄送至保藏中心前,均对其ITS或线粒体SSU区域进行了再次测序以复核。仅当BLAST比对结果确认其身份符合预期后,培养物才会被送至菌种保藏中心。这些菌株已提交至 CBS-KNAW(荷兰皇家科学院真菌生物多样性中心)保藏。
3 结果
总体而言,促进孢子萌发的最佳培养基是燕麦片培养基、马铃薯-胡萝卜琼脂培养基以及YES培养基。尽管未系统比较相对生长速率,但热带壳状地衣在无菌培养中最为成功且生长最快。
黄枝衣目地衣在燕麦片和马铃薯-胡萝卜琼脂培养基上生长良好。而肺衣目及相近的皮果衣属地衣(蓝藻型地衣)在本文所述的所有培养基上均未能生长。
一旦孢子萌发且培养物生长至足够量,便可将真菌块均质化并转移至液体摇瓶培养。为最大限度降低污染风险,液体培养几乎只使用MY和NMBBM培养基。
大部分丢失的培养物均发生在此阶段之后,原因包括污染、过度均质化或均质化不足。总体而言,我们发现每月进行一次均质化足以维持培养物活性;而更频繁的均质化虽偶尔能被耐受,但最终会导致培养物死亡。均质化间隔超过三个月的液体培养物很难恢复活性。
为防止过度均质化采取的一项保护性策略是,在均质化前取出少量液体培养物,将其维持在液体或固体培养基中保存。同样,保留多份备用平板或斜面也至关重要。定期将液体培养物直接转接至固体培养基,或转接至铺在固体培养基上的滤膜圆片以维持培养物健康,或许也是可取的策略,尽管本研究中未测试此方法。
本研究获得的地衣化真菌无菌培养物清单见表1,其中包括分类学信息、本研究新生成序列的Genbank登录号,以及本研究和其它研究(Armaleo and May 2009; Armaleo et al. 2011; McDonald 2011; McDonald et al. 2012)中对特定菌株进行测序的基因总数。此外,图1展示了代表本研究所涵盖部分培养物多样性的照片。
已萌发但未能生长超过一至五次细胞分裂,或已萌发并生长至可转移至液体培养的规模但随后丢失的孢子情况。
表1 地衣化真菌培养物分类(依据 Lumbsch 与 Huhndorf 2010 分类系统)、其对应菌种保藏编号与Genbank登录号
| Taxon | Isolator | Subclass | Order | Culture Bank Accession no. | GenBank ITS Accession no. | GenBank mitSSU Accession no. | Sequencing Level |
|---|---|---|---|---|---|---|---|
| Acarospora cf. contigua | TM | Acarosporomycetidae | Acarosporales | CBS 132361 | KC592261 | KC592293 | 2+19(a)+(b) |
| Acarospora socialis | TM | Acarosporomycetidae | Acarosporales | CBS 132362 | KC592262 | KC592280 | 2+(b) |
| Acarospora strigata | TM | Acarosporomycetidae | Acarosporales | CBS 132363 | KC592263 | — | 1+19(a)+G(b) |
| Astrothelium galbineum | EG | Dothideomycetes (Class) | Trypetheliales | CBS 132364 | KC592264 | — | 1+8(a) |
| Cladonia cristatella | TM | Lecanoromycetidae | Lecanorales | CBS 132749 | KC592270 | — | 1+23(a)+(b) |
| Cladonia grayi | DA | Lecanoromycetidae | Lecanorales | CBS 132746 | KC592272 | — | 25(a)+G(c)+(b) |
| Cladonia peziziformis | TM | Lecanoromycetidae | Lecanorales | CBS 132365 | KC592271 | — | 1+(b) |
| Graphis handelii | TM | Ostropomycetidae | Ostropales | CBS 132366 | — | KC592281 | 1+(b) |
| Graphis scripta | TM | Ostropomycetidae | Ostropales | CBS 132367 | KC592274 | — | 1+23(a)+G(b) |
| Graphis sp. | TM | Ostropomycetidae | Ostropales | CBS 132747 | — | KC592282 | 1+(b) |
| Ionaspis alba | TM | Ostropomycetidae | Incertae sedis | CBS 132748 | KC592264 | — | 1+(b) |
| Leiorreuma sericeum 1 | TM | Ostropomycetidae | Ostropales | CBS 132368 | KC592265 | KC592283 | 2+(b) |
| Leiorreuma sericeum 2 | TM | Ostropomycetidae | Ostropales | CBS 132369 | KC592266 | KC592284 | 2+(b) |
| Phaeographis elliptica | EG | Ostropomycetidae | Ostropales | CBS 130777 | KC592276 | KC592285 | 2 |
| Platygymne sp. | EG | Ostropomycetidae | Ostropales | CBS 130778 | KC592277 | KC592286 | 2 |
| Polymeridium subcineruem | EG | Dothideomycetes (Class) | Trypetheliales | CBS 130779 | KC592279 | KC592287 | 2 |
| Pyrenula cruenta 1 | TM | Chaetothyriomycetidae | Pyrenulales | CBS 132370 | KC592288 | KC592288 | 1+16(a)+(b) |
| Pyrenula cruenta 2 | EG | Chaetothyriomycetidae | Pyrenulales | CBS 132371 | KC592267 | — | 1 |
| Pyrenula cruenta 3 | EG | Chaetothyriomycetidae | Pyrenulales | CBS 132372 | KC592268 | — | 2 |
| Pyrenula cruenta 4 | EG | Chaetothyriomycetidae | Pyrenulales | CBS 132373 | KC592269 | — | 1 |
| Pyrenula ochraceoflava | EG | Chaetothyriomycetidae | Pyrenulales | CBS 132741 | KC592275 | KC592289 | 2 |
| Trypethelium aeneum | EG | Dothideomycetes (Class) | Trypetheliales | CBS 132743 | KC592278 | — | 2+(b) |
| Trypethelium eluteriae | EG | Dothideomycetes (Class) | Trypetheliales | CBS 132375 | KC592273 | KC592290 | 1+15(a) |
| Trypethelium virens 2 | TM | Dothideomycetes (Class) | Trypetheliales | CBS 132374 | — | KC592292 | 1+(b) |
| Usnea strigosa | TM | Lecanoromycetidae | Lecanorales | CBS 132745 | KC592273 | — | 1+(b) |
分离者姓名缩写:EG 代表 Ester Gaya,TM 代表 Tami McDonald,DA 代表 Daniele Armaleo。对于未设亚纲的类群,直接列出其纲名。最后一列显示了每个菌株已测序的基因数量或获得的平均基因组覆盖度。数字旁边括号内的字母指向包含该测序数据的出版物:a. Miadlikowska 等(未发表数据);b. McDonald (2011) 与 McDonald 等 (2012);c. Armaleo 与 May (2009) 及 Armaleo 等 (2011)。若菌株已完成全基因组测序,则以字母G标注(数据可在 http://genome.jgi.doe.gov/Clagr2/Clagr2.home.html 获取)。未附带字母的数字代表本研究中测序的基因数量。
图1、地衣化真菌培养物。a. 紧密微泡衣于NMBBM培养基;b. 淡黄星盾炱于MY培养基;c. 椭圆暗文字衣于OAT培养基;d. 浅灰多隔孢衣于NMBBM培养基;e. 血红小核衣于NMBBM培养基;f. 粗皮松萝于MY培养基。所有比例尺 = 2毫米。
4 讨论
本文所使用的五种培养基组合,似乎足以诱导大多数地衣化真菌的孢子萌发,但与蓝藻共生的地衣化真菌是显著例外。与蓝藻共生的柱状皮果衣的孢子在所有供试培养基上均未萌发。同样,肺衣属、猫耳衣属、胶衣属以及肺衣在内的肺衣目地衣,在本实验条件下也未萌发,或虽萌发但生长不超过数次细胞分裂。额外使用活体或灭菌的念珠藻培养物(非从地衣中分离)制备的培养基,亦未能诱导肺衣属孢子萌发。或许,如先前报道所述,在来自同一地衣体的蓝藻培养物上接种孢子可能诱导其萌发。
一个尚未探讨的考虑因素是反复破碎处理带来的长期影响。液体培养的非自然条件可能对地衣化真菌造成很大压力,并可能实际上对培养物施加强大的选择压力。因此,培养物除了积累点突变外,还可能经历大规模基因组效应,如非整倍性或基因组重排。这些事件可能随着均质化传代次数和培养总时长的增加而增多。为测试培养条件对基因组完整性的影响,对同一培养物在不同年份的系列分离株进行冻存,并在不同时间点对其基因组进行测序,将是一个有趣的实验。事实上,此类实验对于确定已测序的真菌共生体培养物的基因组是否足以代表自然界中地衣化真菌的基因组至关重要。如果基因组重排或其他培养导致的基因组人为改变被证明是一个问题,则需要开发新的低温保存方法。其他真菌可轻松以酵母细胞或分生孢子的甘油悬液形式冻存,从而最小化传代次数和可能积累突变的培养时间;然而,培养的地衣化真菌缺乏上述细胞类型,因此必须以菌丝片段形式保存。冷冻菌丝片段用于维持地衣化真菌培养物的有效性在很大程度上尚未得到探索。
随着地衣学进入基因组学时代,培养地衣真菌共生体和光合共生体的重要性日益增加。大量资源已投入真菌测序,仅通过Genbank即可获取超过179个真菌基因组(截至2012年10月)——远超任何其他真核生物类群。如今,主要真菌目代表种及许多重要病原菌的基因组已被测序,注意力正转向代表性不足的真菌类群,特别是具有特殊习性和生境的真菌。地衣化真菌当然是其中之一。测序机构要求提供高达150微克的DNA和50微克的RNA,以从头测序达到发表质量的基因组。理想情况下,这些DNA和RNA应来自纯培养物。获取如此数量的DNA和RNA需要数瓶或数板培养物,这对于地衣化真菌而言可能意味着数年的生长。令人兴奋的是,Illumina公司的HiSeq短读长技术等新一代测序平台,仅需1微克DNA即可完成基因组测序。利用该平台,我们将八个地衣化真菌的基因组混合在三个测序通道中,实现了50倍及更高的覆盖度。
由于基因敲除和转化等常用遗传技术尚未在任何地衣系统中建立,基因组学成为探索地衣化分子机制的一个有吸引力的替代途径。有了基因组数据,就有可能探索地衣化真菌在非共生状态(真菌与其藻类分开培养)与共生状态下激活或沉默的基因网络。凭借多个地衣基因组,科学界可以开展比较基因组学研究,并寻找亲缘关系甚远的地衣类群所共有的基因,以确定远缘的地衣化真菌是否采用相同或不同的方式与其光合共生体进行信号交流和相互作用。也可以搜索特定基因的存在与否,正如McDonald (2011) 对铵转运蛋白所做的那样。拥有从同一地衣体分离的双方共生体培养物,其最大益处之一是能够进行体外重合成实验,并进行转录组学和蛋白质组学研究,以检测与地衣共生早期阶段相关的差异基因表达。我们希望这些菌株在公共菌种库中的可获取性,将吸引研究人员开展此类实验,并鼓励他们将所培养的地衣共生体提交至公共菌种库。
总结
这项工作解决了地衣真菌培养物稀缺且难以维持的长期难题,其技术细节与公共资源保藏举措,将极大推动地衣共生机制的基因组学、转录组学及体外重合成等实验研究,为解析地衣这一经典共生体系的分子基础打开了新的窗口。
参考文献
https://link.springer.com/article/10.1007/s13199-013-0228-0
相关产品
HZB585449:Usnea strigose CBS 132745
敬请关注灰藻生物,共筑健康未来!
— 武汉市灰藻生物科技有限公司团队敬上
灰藻生物:我们期待着与客户共同成长,共创生命科学的美好未来!
更新日期:2026-01-31
编制人:小灰
审稿人:小藻